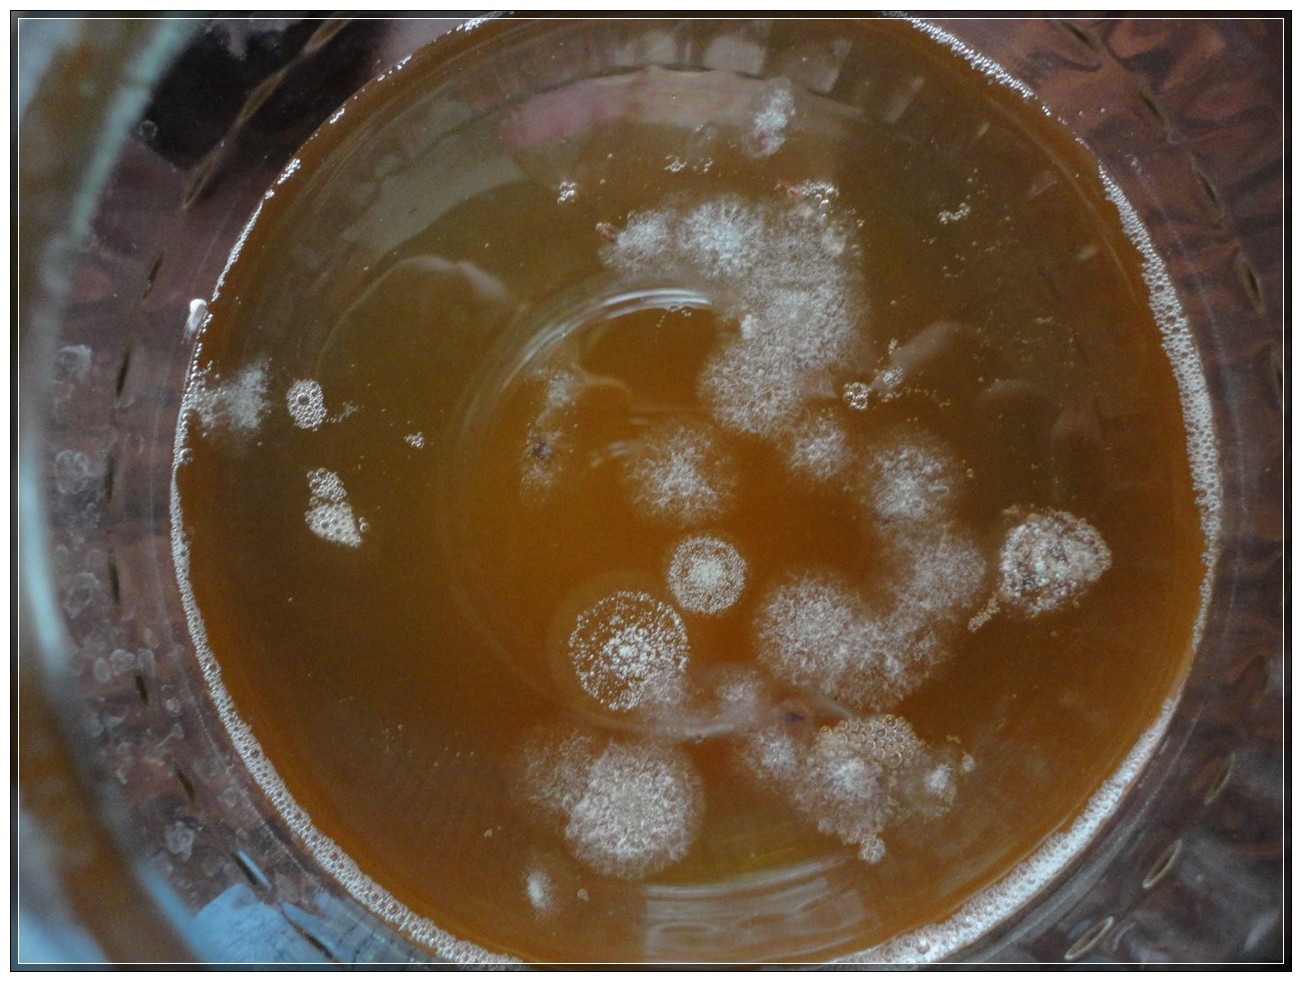

20세기에 잠시 잊혔던 건강 음료 콤부차가 다시 인기를 얻고 있습니다. 콤부차를 얻기 위해 이웃이나 친구들 사이에서 머쉬룸 바디를 찾거나 온라인으로 주문할 필요가 없습니다. 집에서 콤부차를 직접 재배하는 것은 매우 쉽지만, 시간이 좀 걸립니다.
버섯의 특징과 성질
언뜻 보기에 버섯과 닮은 이 생물은 메두소미세스(medusomyces), 차해파리, 일본 여왕버섯, 팡가(fanga), 만주버섯, 일본버섯, 콤부차(kombucha)로도 알려져 있습니다. 흰색과 분홍빛을 띤 두꺼운 황갈색 막(주글레아)은 보통 달콤하고 농축된 차잎 표면에 떠다니며, 차잎은 이 막의 영양 배지 역할을 합니다. 메두소미세스는 이 배지를 여러 가지 유익한 성분을 지닌 크바스(kvass)와 같은 음료로 변형시킵니다.
이 유기체는 실제로 유기산(글루콘산, 구연산, 옥살산, 젖산, 탄산산, 사과산, 아세트산), 카페인, 비타민, 효소, 설탕, 와인 알코올, 퓨린 물질을 생성하는 많은 미생물, 효모균, 아세트산 박테리아의 군집이라는 점을 이해하는 것이 중요합니다.
분리된 층에서 버섯 재배
집에서 콤부차를 제대로 재배하는 방법은 여러 가지가 있습니다. 가장 흔한 방법은 다 자란 주공(zooglea)을 나누는 것인데, 주공은 다 자라면 여러 층으로 구성됩니다. 층의 표면은 매끄럽지만, 물에 잠긴 층은 섬유질이 많고 느슨합니다.
버섯을 조심스럽고 조심스럽게 개별 접시에 담아 영양이 풍부한 차에 담가 두면 버섯의 성장과 번식이 촉진됩니다. 버섯이 아직 어리고 바닥까지 가라앉았다면, 반투명한 겉껍질을 벗겨내면 영양 배지에서 새로운 유영균(zogloea)으로 자랄 수 있습니다.
주글리아는 겨울과 가을보다 봄과 여름에 더 잘 자라는 것으로 관찰되었습니다. 마시기 전에 네 겹으로 접은 무명천에 걸러 마시는 것이 좋습니다.
집에서 처음부터 콤부차를 재배하는 단계별 레시피
집에서 티 크바스를 만드는 것은 충분히 가능하지만, 단계별 지침을 따르고 실수를 피해야 합니다. 버섯 자체를 키우는 데는 최소 5주가 걸립니다. 여름에는 단 3일, 추운 계절에는 7일 만에 음료를 준비할 수 있습니다.
이 크바스는 더운 날씨에는 최대 72시간, 겨울에는 최대 5일 동안 냉장고에 보관할 수 있습니다. 최대 한 달 동안 숙성시킨 후에는 미용 목적, 헹굼, 또는 찜질팩으로 외용으로 사용할 수 있습니다. 두께가 4cm 이상인 오래된 버섯은 나누어 심거나 버려야 합니다. 버섯에서 나오는 음료가 더 이상 유익하지 않기 때문입니다.
클래식 티 레시피
차를 재배하는 첫 번째 단계는 기본적인 차를 우려내는 것입니다. 끓는 물 1리터당 마른 찻잎 2티스푼을 넣고 평소처럼 차를 우려냅니다. 차를 우려낸 후 걸러내고 설탕 2~3큰술을 넣습니다.
두 번째 단계는 준비된 차에서 곰팡이가 발아하도록 하는 것입니다. 병을 천이나 거즈로 덮고 따뜻하고 어두운 곳에 약 5주 동안 보관합니다. 그러면 표면에 해파리 곰팡이 막이 형성됩니다. 병을 옮기거나, 용액을 저어주거나, 뚜껑을 열어두는 것은 좋지 않습니다. 각다귀를 유인하거나 곰팡이가 생길 수 있습니다.
새로 자란 버섯은 차에서 매우 조심스럽게 꺼내고, 끓인 따뜻한 물로 여러 번 부드럽게 헹군 후 새로운 환경에 놓아야 합니다.
로즈힙과 함께
로즈힙으로 콤부차를 재배하는 방법에는 두 가지가 있습니다. 바로 장기 재배와 빠른 재배입니다. 장기 재배의 경우, 소독된 보온병에 말린 콤부차나 생 콤부차 10~15개를 넣고 끓는 물 0.5리터를 부으세요. 그런 다음, 뚜껑을 꼭 닫고 약 두 달 동안 우려내세요.
그 결과, 액체 표면에 얇은 막 같은 물질이 나타납니다. 이 물질은 따뜻한 끓인 물에 조심스럽게 헹군 후, 식힌 차 용액(가급적 3리터 병이나 주전자)에 옮겨 담습니다. 물 1리터당 건조 차 2티스푼을 넣고 기호에 따라 설탕을 넣어 우려냅니다.
빠른 방법으로는 로즈힙을 보온병에 일주일 정도 담가둔 후, 걸러낸 차액을 차 용액(끓는 물 1리터당 마른 차잎 4큰술과 설탕 20큰술)에 넣습니다. 어둡고 따뜻한 곳에 보관하면 한 달 반 안에 버섯이 자랄 것입니다. 이 해파리버섯의 추가 관리 방법은 일반 해파리버섯과 동일합니다.

사과 주스와 함께
일반 천연 사과 주스로도 차 해파리를 만들 수 있습니다. 주스를 밀봉하지 않고 통풍이 잘 되는 용기에 담아 따뜻하고 어두운 곳에 몇 달 동안 보관하면 됩니다.

수액 표면에 두껍고 촘촘한 막이 형성됩니다. 이 막을 깨끗이 헹군 후, 설탕을 넣은 따뜻한 차에 옮겨 담습니다. 버섯을 관리하는 방법은 일반적인 재배 방법과 비슷합니다.
맥주에 관하여
저온살균되지 않은(생맥주) 맥주로 재배한 버섯을 사용하여 티 크바스를 만들면 특별한 풍미를 얻을 수 있습니다. 이를 위해서는 맥주 100g, 설탕 한 티스푼, 그리고 사워 와인 몇 티스푼이면 충분합니다.
혼합물을 따뜻하고 어두운 곳에 두고 천으로만 덮은 후, 표면에 막이 형성될 때까지 저어주지 않고 그대로 두세요. 그런 다음 씻어서 새 차에 조심스럽게 옮겨 담아 더 잘 자라게 하세요. 직접 만든 크바스를 사용해도 됩니다. 버섯이 자라면서 7~10일마다 차의 액을 주기적으로 갈아주고 버섯 자체도 깨끗이 헹궈주세요.
허브에 관하여
티 크바스를 더욱 영양가 있고 유익하며 향긋하고 상쾌하게 만들려면 오일과 열매가 없는 신선하고 말린 약초를 차에 첨가할 수 있습니다.

으깬 플랜틴, 자작나무, 쐐기풀 잎, 로즈힙, 블랙베리, 딸기 등이 이 목적에 적합합니다. 설탕 대신 꿀을 소량 첨가할 수 있지만, 차가운 차에는 반드시 넣어야 합니다.
사과식초와 함께
방부제나 색소가 첨가되지 않은 천연 사과 식초만이 주글로아 발아에 적합합니다. 신선한 사과로 직접 만들 수도 있습니다. 개봉한 식초를 따뜻하고 어두운 곳에 3개월 동안 두면 용기 바닥에 침전물이 생깁니다. 다음 단계는 액체를 걸러내고 침전물을 실온에서 차와 설탕을 넣은 물에 조심스럽게 붓는 것입니다. 이 영양 배지는 결국 완전한 콤부차로 성장하게 됩니다.

잘 알려지지 않았지만 꽤 간단한 해파리 기르기 방법은 찻주전자에 곰팡이를 심는 것입니다. 곰팡이를 시원하고 진한 찻주전자에 설탕과 함께 넣습니다. 곰팡이가 완전히 자라면 뒤집어서 새 차에 옮겨 담고 다시 한 번 뒤집어 줍니다. 버섯이 충분히 자라면 사과 식초에 5분간 담갔다가 깨끗한 물로 깨끗이 헹군 후 평소처럼 사용합니다.
자주 묻는 질문에 대한 답변
버섯 재배와 관련하여 많은 질문이 있습니다.
외부 증상이 변하지 않으면 먼저 실온에서 끓인 물로 깨끗이 헹군 다음, 신선한 차 용액에 담아 필요한 온도 체계를 만들어야 합니다.
콤부차는 건강하고 영양가 있으며 맛있는 음료로, 갈증을 완벽하게 해소하고 위장 기능을 정상화하며 건강 문제 완화에 도움을 줍니다. 집에서 콤부차를 재배하는 것은 어렵지 않지만, 몇 가지 필수 지침을 따라야 합니다.

느타리버섯은 사람에게 어떤 이점과 해로움이 있나요? (+27장 사진)
소금에 절인 버섯에 곰팡이가 생기면 어떻게 해야 하나요? (+11장 사진)
관형으로 간주되는 버섯은 무엇이며 그 설명은 다음과 같습니다(+39개 사진)
2021년 모스크바 지역에서는 언제, 어디에서 꿀버섯 따기를 시작할 수 있나요?